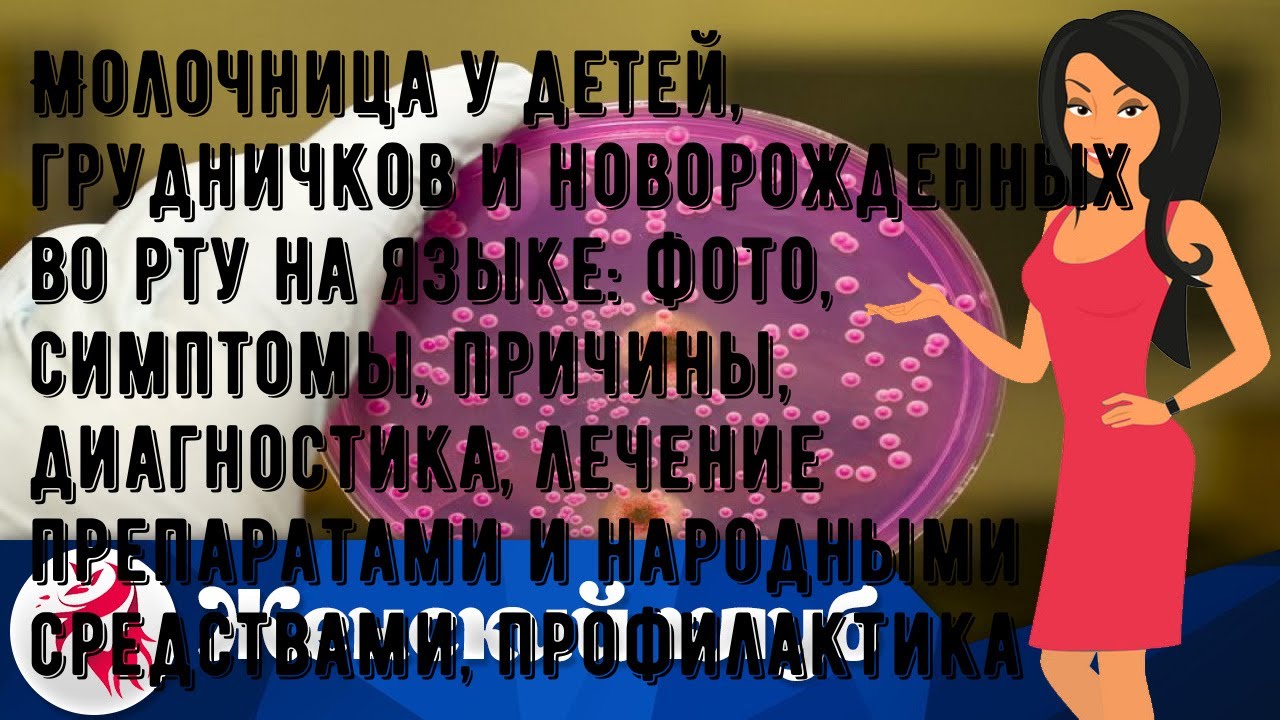

Молочница у ребенка мкб
Молочница у ребенка мкб 114 фото
Месячные операция форум
Inspiring skills
Русский подкаблучник
Всемирный день книги цель
Пасхальное яйцо шаблон для раскрашивания для детей
Как использовать чистотел для лечения
Альберо браш
Аккумулятор giver 60
Грибы копы ремикс
Шины камаз 260